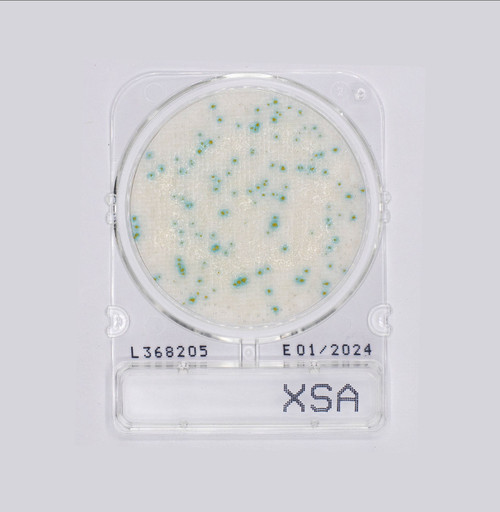
Compact Dry™ XSA Ready to Use Medium For Staphylococcus aureus Testing

Compact Dry ETB is used for enumeration of Enterbacteriacae in food products and food environments helps to monitor the degree of cleanliness and sanitation.
Traditional plate methods have been widely used to determine microbial counts, but these methods are time-consuming and require media preparation.
To save operator time and make it possible for anyone to perform the microbial count test without difficulty, Compact Dry was developed based on a new concept and technology applicable to the food industry.
Compact Dry ETB is a simplified medium to determine number of Enterobacteriaceae by the combination of selective agents and a pH indicator.
Ship and store at room temperature. No need for a refrigerator!
Certification by AOAC!
Compact Dry ETB has been compared to ISO 21528-2:2014 and certified by the AOAC Research Institute Performance Tested Methods Program (Certificate No. 012001) for enumeration of Enterobacteriaceae in raw ground beef, cooked chicken, lettuce (pre-washed, bagged, shredded iceberg), frozen fish (cod fillets), instant nonfat dry milk powder and pasteurized milk (2%), pasteurized cream, cream cheese, ready-to-cook fresh vegetables, vegetable juice, raw ground pork, raw bacon, fresh-cooked prawns, fish pâté, and cooked, chilled rice. Microval validation certified method in compliance with ISO 16140-2:2016 in comparison to ISO 21528-2:2014
-
Rigid frame with aerobic headspace
-
No need for spreader
-
Stack up to 60 plates
-
Room temperature storage
-
Easily select intact colony for confirmation
-
No interpretation of gas bubbles
-
Gamma irradiated post packaging
Click on the icon below to view a copy of the kit insert
Click on the icon below to view a copy of the testing protocol and interpretation
Click on the icon below to view a copy of the AOAC certification